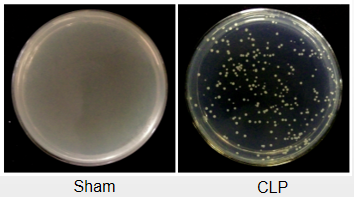
做实验动物疾病模型，云克隆是认真的

做实验动物疾病模型,云克隆是认真的
2021-01-20 09:25点击次数:564
关键词:实验动物疾病模型的研究让以人本身作为实验对象来探讨疾病的发生机制成为现实,借助于动物模型的研究,可以更方便、有效地认识人类疾病的发生发展规律,研究防治措施。我们有SPF级动物房,大量的造模经验,专业的造模团队,完备的造模设备,可提供包括心血管系统、消化系统、呼吸系统、血液系统、神经系统、泌尿系统等多种系统在内的疾病动物模型的建模服务。
先为大家分享客户咨询最多的几种模型案例:
1. 脑梗、心梗模型
大脑中动脉阻塞 (middle cerebral artery occlusion,MCAO) 是目前最常用的局灶性脑缺血模型,采用线栓法造模,从颈外动脉(ECA)插入尼龙线,经颈内动脉(ICA)到大脑前动脉(ACA),机械性阻断大脑中动脉(MCA)发出处的血供来建立大脑中动脉缺血模型。此模型可在无麻醉状态下拔出尼龙线,恢复血流,实现再灌注。线栓法具有不开颅、效果肯定、可准确控制缺血及再灌注时间的优点。
心肌梗死模型通过结扎左冠状动脉前降支(LAD)法致心梗,于显微镜下找到LAD走向或可能所在位置,持针器持取7-0带针缝合线,于左心耳下缘2mm处进针,缝线穿过LAD,以完全阻断LAD血流。模型可通过二维M-模式心动图和心脏组织TTC染色进行评价。

图1. B超检测心梗模型心脏
下图是我们对Sham组和脑梗、心梗模型鼠脑组织、心组织的TTC染色结果图,白色为梗死组织,红色为正常组织,可以清晰的看到模型组出现了明显的梗死。

图2. Sham组和脑梗、心梗模型组脑组织(左)和心脏组织(右)TTC染色
2. 脓毒症模型
盲肠结扎穿孔术(CLP)造成的混合型细菌感染动物模型被认为是研究脓毒症动物模型中的经典模型,我们通过此方法成功建立了脓毒症动物模型,并可通过检测血样中的相关炎症因子,术后24h血液平板涂布图及菌落数统计,肺组织、肠组织病理染色等相关检测对模型进行评价。
图3. 脓毒症模型血液平板涂布
3. 抑郁症模型
我们采取目前国际最为公认的CUMS法建立抑郁症模型,可提供多种不同的应激刺激,如:昼夜颠倒,放置异物,冰水游泳,噪音,0℃暴露,禁食禁水,倾斜鼠笼,禁食不禁水,尾巴挤压,热应激,水平振荡,湿笼,行为限制,电击(30V电压)足底等。造模完成后,可通过蔗糖实验、旷场试验、游泳实验、体重变化和食物消耗来评价抑郁症模型是否成功。
选择合适的行为学实验是研究不同疾病模型的重要研究手段。既然前面提到了旷场试验,那就不得不说一下我们的行为学实验。
我们可提供的行为学检测涉及多个方向,包括:学习与记忆行为学(如:Morris水迷宫实验、避暗实验、穿梭实验),焦虑与抑郁行为学(如:高架十字迷宫、悬尾实验、黑白箱/明暗箱实验),药物成瘾行为学(如:爬壁行为实验),疼痛行为学(如:Von Frey痛觉测试、冷热板测痛),神经精神异常行为学(如:旷场实验),疲劳行为学(如:转棒实验、强迫游泳实验、跑台实验)。

图4. 小动物旷场试验

图5. 部分行为学检测设备
在疾病模型建模中,需要用到各种操作设备,如:动物保温箱、脑立体定位仪、颅脑打击器、小动物呼吸机、手术用体视显微镜、肝温仪、血糖仪、雾化发生器,低氧环境饲养箱,生化分析仪,血常规分析仪,小动物活体成像系统等。
下图展示部分建模相关设备:

图6. 建模相关设备
我们的资质
我公司拥有湖北省科学技术厅颁发的《实验动物生产许可证》,同时还具有大动物和小动物《实验动物使用许可证》。

图7. 《实验动物生产许可证》和《实验动物使用许可证》
更多动物疾病模型,欢迎大家致电咨询:027-84856560,027-84259828
或访问我们的官方网站:http://www.cloud-clone.com.cn/diseaseModels.html



